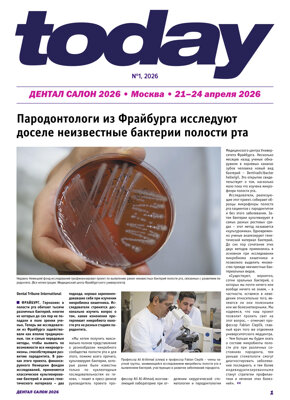
today Dental Salon Moscow April 21–24, 2026

E-papers
E-paper editions are exact digital copies of the DTI print publications. Readers can search and navigate through the e-paper, as well as download and print pages to read offline. In order to promote wide dissemination to our international readership, access to most e-papers is free.
today Dental Salon Moscow April 21–24, 2026
Пародонтологи из Фрайбурга исследуют доселе неизвестные бактерии полости рта / Интервью с И.И. Бродецким, генеральным директором АО «ДЕ-5» (ВК «ДЕНТАЛЭКСПО») / Рекомендованный уровень фторирования воды и когнитивные способности подростков – что новое исследование говорит об их связи? / Floor plan / «Быть примером для подражания – один из самых благодарных способов передачи знаний и опыта» / «Связь пародонтита и системных заболеваний особенно значима в случае мужчин» /
- Пародонтологи из Фрайбурга исследуют доселе неизвестные бактерии полости рта 1 - 1
- Интервью с И.И. Бродецким, генеральным директором АО «ДЕ-5» (ВК «ДЕНТАЛЭКСПО») 2 - 2
- Рекомендованный уровень фторирования воды и когнитивные способности подростков – что новое исследование говорит об их связи? 3 - 3
- Floor plan 4 - 5
- «Быть примером для подражания – один из самых благодарных способов передачи знаний и опыта» 6 - 7
- «Связь пародонтита и системных заболеваний особенно значима в случае мужчин» 7 - 8



 Brazil / Brasil
Brazil / Brasil
 Canada / Canada
Canada / Canada
 Latin America / Latinoamérica
Latin America / Latinoamérica
 USA / USA
USA / USA
 Austria / Österreich
Austria / Österreich
 Bosnia and Herzegovina / Босна и Херцеговина
Bosnia and Herzegovina / Босна и Херцеговина
 Bulgaria / България
Bulgaria / България
 Croatia / Hrvatska
Croatia / Hrvatska
 Czech Republic & Slovakia / Česká republika & Slovensko
Czech Republic & Slovakia / Česká republika & Slovensko
 France / France
France / France
 Germany / Deutschland
Germany / Deutschland
 Greece / ΕΛΛΑΔΑ
Greece / ΕΛΛΑΔΑ
 Hungary / Hungary
Hungary / Hungary
 Italy / Italia
Italy / Italia
 Netherlands / Nederland
Netherlands / Nederland
 Nordic / Nordic
Nordic / Nordic
 Poland / Polska
Poland / Polska
 Portugal / Portugal
Portugal / Portugal
 Romania & Moldova / România & Moldova
Romania & Moldova / România & Moldova
 Slovenia / Slovenija
Slovenia / Slovenija
 Serbia & Montenegro / Србија и Црна Гора
Serbia & Montenegro / Србија и Црна Гора
 Spain / España
Spain / España
 Switzerland / Schweiz
Switzerland / Schweiz
 Turkey / Türkiye
Turkey / Türkiye
 UK & Ireland / UK & Ireland
UK & Ireland / UK & Ireland
 China / 中国
China / 中国
 India / भारत गणराज्य
India / भारत गणराज्य
 Pakistan / Pākistān
Pakistan / Pākistān
 Vietnam / Việt Nam
Vietnam / Việt Nam
 ASEAN / ASEAN
ASEAN / ASEAN
 Israel / מְדִינַת יִשְׂרָאֵל
Israel / מְדִינַת יִשְׂרָאֵל
 Algeria, Morocco & Tunisia / الجزائر والمغرب وتونس
Algeria, Morocco & Tunisia / الجزائر والمغرب وتونس
 Middle East / Middle East
Middle East / Middle East





















